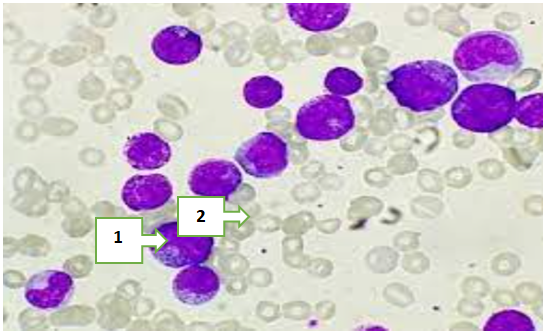

-
Paper Information
- Next Paper
- Previous Paper
- Paper Submission
-
Journal Information
- About This Journal
- Editorial Board
- Current Issue
- Archive
- Author Guidelines
- Contact Us
American Journal of Medicine and Medical Sciences
p-ISSN: 2165-901X e-ISSN: 2165-9036
2025; 15(11): 4095-4098
doi:10.5923/j.ajmms.20251511.76
Received: Oct. 13, 2025; Accepted: Nov. 10, 2025; Published: Nov. 24, 2025

Morpho-Clinical Characteristics of Pediatric Acute Myeloblastic Leukemia
Tashbaev Alisher Bakhriddinovich1, Mamajanov Bakhodirjon Solijanovich2
1Independent Researcher, Andijan State Medical Institute, Andijan, Uzbekistan
2Professor, Andijan State Medical Institute, Andijan, Uzbekistan
Correspondence to: Tashbaev Alisher Bakhriddinovich, Independent Researcher, Andijan State Medical Institute, Andijan, Uzbekistan.
| Email: |  |
Copyright © 2025 The Author(s). Published by Scientific & Academic Publishing.
This work is licensed under the Creative Commons Attribution International License (CC BY).
http://creativecommons.org/licenses/by/4.0/

Acute myeloblastic leukemia (AML) is an aggressive hematological malignancy observed in children, characterized by impaired hematopoiesis and complex morphological alterations of bone marrow cells. The pathogenesis of AML involves multifactorial mechanisms, including disruption of normal myeloid differentiation, chromosomal abnormalities, and immune dysregulation. The aim of this study was to investigate the morpho-functional characteristics of pediatric AML and to evaluate their clinical relevance. Morphological analysis revealed significant variations in cell structure, nuclear-cytoplasmic ratio, and the degree of blast differentiation, allowing differentiation between distinct AML subtypes. The obtained results demonstrated a clear interrelationship between morphological features and clinical manifestation of the disease, confirming that morphological assessment plays an essential role in improving diagnostic accuracy and prognostic evaluation in pediatric AML.
Keywords: Acute myeloblastic leukemia, Pediatric hematology, Morphology, Blast cells, Diagnosis, Prognosis, Pathogenesis
Cite this paper: Tashbaev Alisher Bakhriddinovich, Mamajanov Bakhodirjon Solijanovich, Morpho-Clinical Characteristics of Pediatric Acute Myeloblastic Leukemia, American Journal of Medicine and Medical Sciences, Vol. 15 No. 11, 2025, pp. 4095-4098. doi: 10.5923/j.ajmms.20251511.76.
Article Outline
1. Introduction
- Acute myeloblastic leukemia (AML) in children remains one of the most complex and heterogeneous hematological malignancies, accounting for approximately 15–20% of all pediatric leukemias and characterized by rapid progression and diverse morphologic variants [1,2]. Despite significant advances in diagnostics and therapy, AML in the pediatric population continues to pose a major clinical and pathological challenge due to its biological diversity and variable response to treatment [3,4].Recent studies indicate that cytogenetic and molecular abnormalities such as RUNX1-RUNX1T1, FLT3-ITD, and NPM1 mutations play a crucial role in the pathogenesis and prognosis of childhood AML [5,6]. Morphologically, these alterations correlate with FAB subtypes M1–M5, reflecting differences in blast cell differentiation, granularity, and nuclear-cytoplasmic ratios [7]. Such histopathological variability underscores the need for a detailed morpho-clinical evaluation of pediatric AML to optimize risk-adapted therapy and predict treatment outcomes [8,9].Clinically, AML in children manifests with nonspecific symptoms including anemia, hemorrhagic syndrome, hepatosplenomegaly, and lymphadenopathy, which often delay diagnosis and complicate disease management [10]. The course of the disease and its response to therapy are also influenced by patient age, bone marrow morphology, and immunophenotypic patterns [11]. Therefore, integrating morphological, immunohistochemical, and clinical characteristics in pediatric AML research provides essential insights into leukemogenesis and potential therapeutic targets [12]. Given the rising incidence and the biological complexity of AML in children, the study of its morpho-clinical spectrum is of high scientific and practical importance. Identifying the structural and cytological features of blast cells, alongside their clinical correlations, is key to improving diagnostic precision, stratifying prognosis, and guiding individualized treatment approaches in pediatric oncohematology [13].
2. Purpose of the Study
- The primary aim of this study is to comprehensively analyze the morphological and clinical characteristics of pediatric acute myeloblastic leukemia (AML), to determine their interrelationship, and to assess the significance of morpho-clinical indicators in evaluating disease progression and prognosis.Within the scope of the research, correlations between morphological parameters (such as the nucleus-to-cytoplasm ratio of blast cells, degree of granularity, nuclear chromatin structure, and presence of Auer rods) and clinical indicators (including anemic, hemorrhagic, and hyperplastic syndromes, hepatosplenomegaly, and lymphadenopathy) were evaluated. Additionally, morphological and clinical variations of AML subtypes were examined based on the FAB classification to determine their diagnostic and prognostic relevance.
3. Materials and Methods
- This study was conducted at the Republican Center of Pathological Anatomy during the period from 2018 to 2024. A total of 48 pediatric cases (ranging from 27-day-old neonates to 15-year-old children) who died from acute myeloblastic leukemia (AML) and underwent postmortem pathological examination were analyzed.All materials were selected based on autopsy protocols and processed using standard histological techniques, including fixation in formalin, embedding in paraffin blocks, and staining with hematoxylin and eosin.During histomorphological analysis, the cytoplasmic and nuclear structures of myeloblast cells, the degree of granulation, the state of nuclear chromatin, and the presence of Auer rods were evaluated. Additionally, the disease variants were classified according to the French–American–British (FAB) classification, and their morpho-clinical features were comparatively assessed.The obtained data were correlated with clinical parameters, and morpho-clinical correlation analysis was performed. The research results were subjected to statistical processing to determine the degree of association between the morphological and clinical manifestations of the disease.
4. Results and Discussion
- All pathomorphological materials were selected in accordance with the protocols of the Republican Center for Pathological Anatomy and prepared using standard histological processing techniques. The tissues were fixed in 10% neutral buffered formalin and subsequently embedded in paraffin blocks. Sections 4–5 μm thick were obtained using a microtome and stained with hematoxylin and eosin (H&E). Microscopic examination was performed under an optical microscope at ×400 magnification.The results of the histomorphological analysis demonstrated that myeloblast cells exhibited marked variability in shape, size, and internal structure, reflecting the heterogeneous nature of the pathological process. The cytoplasm was generally scant, basophilic in color, and appeared either homogeneous or finely granular, with varying degrees of granularity intensity. In some cells, Auer rods were observed needle-shaped or elongated cytoplasmic inclusions considered a key morphological hallmark of myeloid lineage blasts (see Figure 1).
|
|
|
|
|
5. Conclusions
- The present study provides an in-depth morpho-clinical evaluation of pediatric acute myeloblastic leukemia (AML), integrating histopathological findings with clinical data. Statistical analysis of 48 pediatric cases demonstrated significant correlations between cytological characteristics, FAB subtypes, and clinical manifestations. The M1 (minimally differentiated) and M2 (differentiated) subtypes were predominant, accounting for 73% of cases, reflecting the higher frequency of partially differentiated blast populations in this cohort. Age-related distribution revealed the highest incidence in children aged 27 days to 3 years (46%), indicating a potential vulnerability in early infancy, while a slight female predominance (58%) suggests sex-based epidemiological differences in pediatric AML.Hematopoietic abnormalities, including anemia (25%), thrombocytopenia (23%), and neutropenia (21%), were frequent and correlated with the degree of blast proliferation and cytoplasmic granularity. Major direct complications contributing to mortality—such as acute respiratory failure (30%), massive hemorrhages (17%), sepsis and severe infections (15%), multiple organ failure (15%), neurological complications (13%), and tumor lysis syndrome (10%)—highlight the severe systemic impact of AML and the multifactorial nature of disease progression.These findings emphasize the clinical relevance of integrated morpho-clinical assessment in pediatric AML. Understanding the distribution of FAB subtypes alongside associated hematological and systemic complications provides critical insights for risk stratification, prognosis, and therapeutic planning. Early identification of high-risk morphological features and predictive clinical indicators can facilitate timely intervention, improve patient outcomes, and inform tailored management strategies. Furthermore, the study underscores the need for ongoing research to elucidate the pathophysiological mechanisms underlying subtype-specific clinical courses, contributing to evidence-based approaches in pediatric oncology.
 Abstract
Abstract Reference
Reference Full-Text PDF
Full-Text PDF Full-text HTML
Full-text HTML